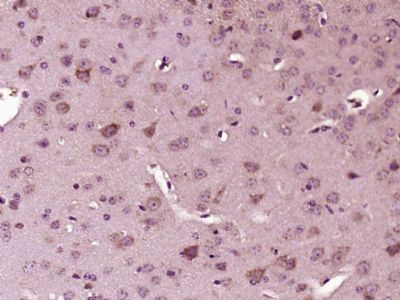
产品封面图

相关产品推荐更多 >
万千商家帮你免费找货
0 人在求购买到急需产品
- 详细信息
- 文献和实验
- 技术资料
- 供应商:
上海康朗生物科技有限公司
- 库存:
大量
- 目录编号:
kl-8709R
- 克隆性:
多克隆
- 抗原来源:
Rabbit
- 保质期:
12个月
- 抗体英文名:
phospho-IRS1 (Tyr1179) antibody
- 抗体名:
磷酸化胰岛素受体底物1抗体
- 宿主:
Rabbit
- 适应物种:
Human, Mouse, Rat, Chicken, Dog, Pig, Cow, Rabbit, Sheep, Guinea Pig, Danio rerio,
- 免疫原:
KLH conjugated synthesised phosphopeptide derived from human IRS1 around the phosphorylation site of Ser1179.:LN(p-Y)ID
- 亚型:
IgG
- 形态:
冻干粉或液体
- 应用范围:
WB=1:500-2000 ELISA=1:500-1000 IHC-P=1:400-800 IHC-F=1:400-800 ICC=1:100-500 IF=1:100-500
- 浓度:
1mg/ml
- 保存条件:
-20 °C
- 规格:
100ul
| 中文名称 | 磷酸化胰岛素受体底物1抗体 |
| 别 名 | IRS1 (phospho S1179); p-IRS1 (phospho S1179); p-IRS1; IRS1(phospho-Ser1179); HIRS 1; HIRS1; Insulin Receptor Substrate 1; IRS-1; IRS 1; IRS1; OTTHUMP00000164234; IRS1_HUMAN. |
| 规格价格 | 100ul/1580元 购买 大包装/询价 |
| 说 明 书 | 100ul |
| 产品类型 | 磷酸化抗体 |
| 研究领域 | 肿瘤 细胞生物 神经生物学 糖尿病 |
| 抗体来源 | Rabbit |
| 克隆类型 | Polyclonal |
| 交叉反应 | Human, Mouse, Rat, Chicken, Dog, Pig, Cow, Rabbit, Sheep, Guinea Pig, Danio rerio, |
| 产品应用 | WB=1:500-2000 ELISA=1:500-1000 IHC-P=1:400-800 IHC-F=1:400-800 ICC=1:100-500 IF=1:100-500 (石蜡切片需做抗原修复) not yet tested in other applications. optimal dilutions/concentrations should be determined by the end user. |
| 分 子 量 | 132kDa |
| 细胞定位 | 细胞膜 |
| 性 状 | Lyophilized or Liquid |
| 浓 度 | 1mg/ml |
| 免 疫 原 | KLH conjugated synthesised phosphopeptide derived from human IRS1 around the phosphorylation site of Ser1179.:LN(p-Y)ID |
| 亚 型 | IgG |
| 纯化方法 | affinity purified by Protein A |
| 储 存 液 | Preservative: 15mM Sodium Azide, Constituents: 1% BSA, 0.01M PBS, pH 7.4 |
| 保存条件 | Store at -20 °C for one year. Avoid repeated freeze/thaw cycles. The lyophilized antibody is stable at room temperature for at least one month and for greater than a year when kept at -20°C. When reconstituted in sterile pH 7.4 0.01M PBS or diluent of antibody the antibody is stable for at least two weeks at 2-4 °C. |
| PubMed | PubMed |
| 产品介绍 | background: Insulin receptor substrates (IRS) are responsible for several insulin related activities, such as glucose homeostasis, cell growth, cell transformation, apoptosis and insulin signal transduction. Serine/threonine phosphorylation of IRS1 has been demonstrated to be a negative regulator of insulin signaling and is responsible for its degradation, although IRS1 degradation pathways are not well understood. IRS1 has also been shown to be constitutively activated in cancers such as breast cancer, Wilm's tumors, and adrenal cortical carcinomas, thus making IRS1 phosphorylation and subsequent degradation an attractive therapeutic target. To date there have been four subtypes identified: IRS1, 2, 3 and 4, with IRS1 being widely expressed. Function : May mediate the control of various cellular processes by insulin. When phosphorylated by the insulin receptor binds specifically to various cellular proteins containing SH2 domains such as phosphatidylinositol 3-kinase p85 subunit or GRB2. Activates phosphatidylinositol 3-kinase when bound to the regulatory p85 subunit. Function: May mediate the control of various cellular processes by insulin. When phosphorylated by the insulin receptor binds specifically to various cellular proteins containing SH2 domains such as phosphatidylinositol 3-kinase p85 subunit or GRB2. Activates phosphatidylinositol 3-kinase when bound to the regulatory p85 subunit. Subunit: Interacts with UBTF and PIK3CA. Interacts (via phosphorylated YXXM motifs) with PIK3R1. Interacts with ROCK1 and FER. Interacts (via PH domain) with PHIP. Interacts with GRB2. Interacts with SOCS7. Interacts (via IRS-type PTB domain) with IGF1R and INSR (via the tyrosine-phosphorylated NPXY motif). Interacts with ALK. Subcellular Location: Membrane; Single-pass type I membrane protein. Tissue Specificity: Isoform Long and isoform Short are predominantly expressed in tissue targets of insulin metabolic effects: liver, adipose tissue and skeletal muscle but are also expressed in the peripheral nerve, kidney, pulmonary alveoli, pancreatic acini, placenta vascular endothelium, fibroblasts, monocytes, granulocytes, erythrocytes and skin. Isoform Short is preferentially expressed in fetal cells such as fetal fibroblasts, muscle, liver and kidney. Found as a hybrid receptor with IGF1R in muscle, heart, kidney, adipose tissue, skeletal muscle, hepatoma, fibroblasts, spleen and placenta (at protein level). Overexpressed in several tumors, including breast, colon, lung, ovary, and thyroid carcinomas. Post-translational modifications: Serine phosphorylation of IRS1 is a mechanism for insulin resistance. Ser-312 phosphorylation inhibits insulin action through disruption of IRS1 interaction with the insulin receptor. Phosphorylation of Tyr-896 is required for GRB2-binding. Phosphorylated by ALK. Phosphorylated at Ser-270, Ser-307, Ser-636 and Ser-1101 by RPS6KB1; phosphorylation induces accelerated degradation of IRS1. DISEASE: Polymorphisms in IRS1 may be involved in the etiology of non-insulin-dependent diabetes mellitus (NIDDM) [MIM:125853]. Similarity: Contains 1 IRS-type PTB domain. Contains 1 PH domain. SWISS: P35568 Gene ID: 3667 Database links: Entrez Gene: 3667 Human Entrez Gene: 16367 Mouse Entrez Gene: 25467 Rat Omim: 147545 Human SwissProt: P35568 Human SwissProt: P35569 Mouse SwissProt: P35570 Rat Unigene: 471508 Human Unigene: 4952 Mouse Unigene: 10476 Rat Important Note: This product as supplied is intended for research use only, not for use in human, therapeutic or diagnostic applications. |
| 产品图片 | ![]() Sample: A549 Cell (Human) Lysate at 40 ug Hela Cell (Human) Lysate at 40 ug MCF-7 Cell (Human) Lysate at 40 ug Primary: Anti- phospho-IRS1 (Tyr1179) (bs-8709R) at 1/300 dilution Secondary: IRDye800CW Goat Anti-Rabbit IgG at 1/20000 dilution Predicted band size: 132 kD Observed band size: 132 kD ![]() Paraformaldehyde-fixed, paraffin embedded (Mouse brain); Antigen retrieval by boiling in sodium citrate buffer (pH6.0) for 15min; Block endogenous peroxidase by 3% hydrogen peroxide for 20 minutes; Blocking buffer (normal goat serum) at 37°C for 30min; Antibody incubation with (phospho-IRS1 (Tyr1179)) Polyclonal Antibody, Unconjugated (bs-8709R) at 1:400 overnight at 4°C, followed by operating according to SP Kit(Rabbit) (sp-0023) instructionsand DAB staining. |
风险提示:丁香通仅作为第三方平台,为商家信息发布提供平台空间。用户咨询产品时请注意保护个人信息及财产安全,合理判断,谨慎选购商品,商家和用户对交易行为负责。对于医疗器械类产品,请先查证核实企业经营资质和医疗器械产品注册证情况。
文献和实验Using Phospho‐Motif Antibodies to Determine Kinase Substrates
comprising both the phosphorylated residue and the surrounding residues that determine kinase specificity, with degenerate residues taking up the remaining positions. Currently, several categories of phospho?motif antibody are commercially available
Optimized Protocol to Make Phospho-Specific Antibodies that Work
, not simply its level of expression. In this review, we will discuss both the design of the phosphopeptide immunogen and immunization. The affinity purification of the phospho-specific antibody as well as the methods most suitable for characterizing
Absorption Control in Immunohistochemistry Using Phospho-Peptides Immobilized on Magnetic Beads
neutralization of phospho-specific antibodies with phospho-peptides immobilized on magnetic beads. This technique allows for sequestration of antibody–peptide complex from the incubation solution, minimizing the risk of formation of unblocked antibodies capable
技术资料暂无技术资料 索取技术资料